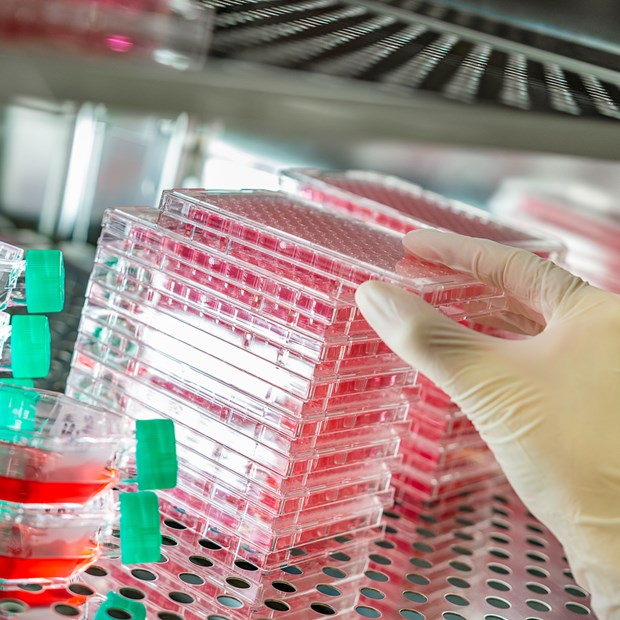

Antibody Services
Custom Polyclonal Antibody Production Services
We produce custom polyclonal antibodies at small and large scales in various host species from small rodents to large animals. Our fast polyclonal antibody production program - Speedy 28-Day - generates a strong and quick immune response in only 28 days of immunization. We can also adapt our protocols to the customer’s project.
Polyclonal Antibody Production
We produce serum and deliver purified antibodies from small to large immunized animals.
Polyclonal antibody preparation is performed according to our standard or fast polyclonal programs. We can also adapt our protocols upon discussion with the customer.
Antibodies against Post-translational Modifications
We produce antibodies against PTMs by immunization of rabbits, rats, or guinea pigs.
Besides our strong expertise in producing phospho specific antibodies, we can generate custom antibodies against acetylation, methylation and more complex PTMs.
Camelid antibody & VHH production
We offer custom polyclonal antibody generation from alpaca and llama immunization.
We also develop and produce single domain antibody - VHH from Heavy-Chain only antibodies exclusively found in Camelids.
Industrial production of antibodies
We are equipped and trained for large scale antibody production. We can produce and deliver large volumes of serum or of purified monoclonal and polyclonal antibodies.
We also have significant expertise in long-term project management and can supply multiple antibody batches successively over time.